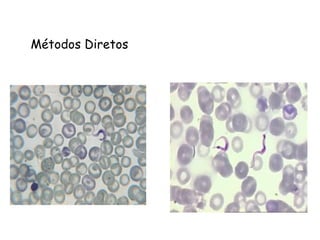
Métodos Diretos

O documento discute a Doença de Chagas, incluindo seu histórico de descoberta, prevalência global, situação atual no Brasil, agente etiológico, vetores, reservatórios, ciclo de vida, formas de transmissão, sinais e sintomas agudos e crônicos, diagnóstico e tratamento.